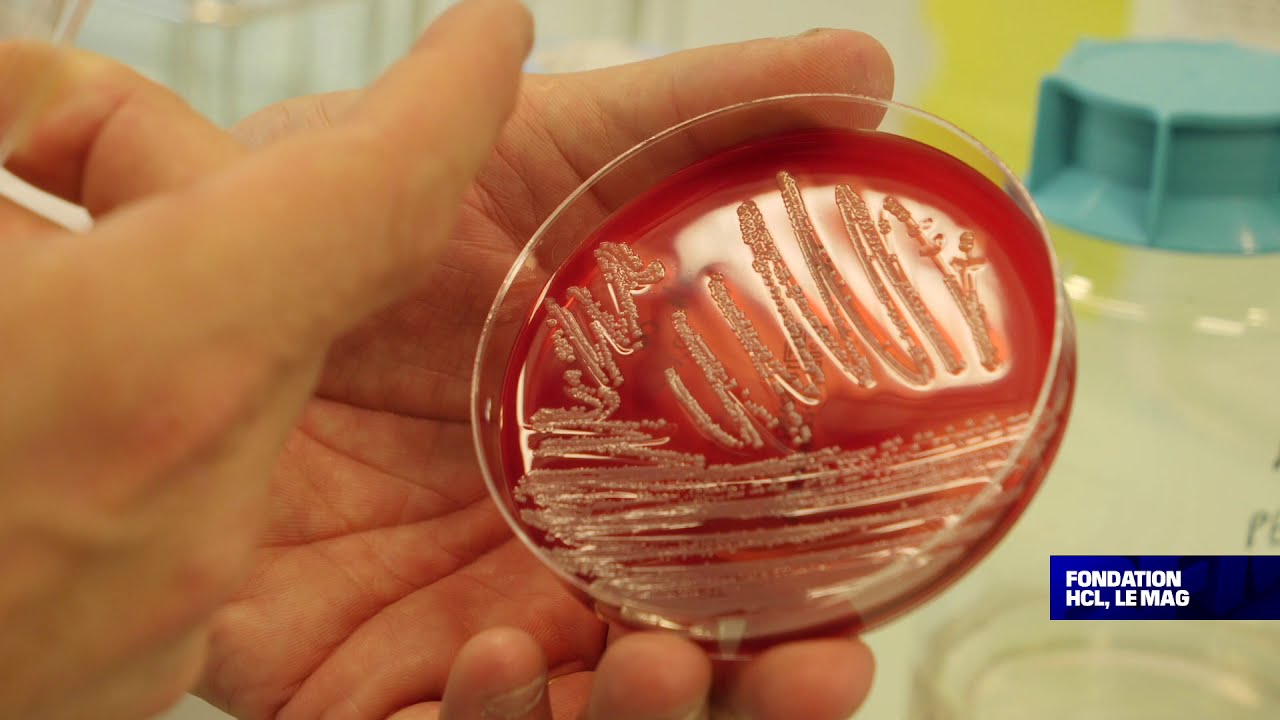
Les bactériophages, des virus mangeurs de bactéries… | Fondation HCL, le mag

Скачать или смотреть Dépistage de l'endométriose : un test salivaire sûr à 95%
-
2025-02-13
-
1008

Скачать Dépistage de l'endométriose : un test salivaire sûr à 95% бесплатно в качестве 4к (2к / 1080p)
У нас вы можете скачать бесплатно Dépistage de l'endométriose : un test salivaire sûr à 95% или посмотреть видео с ютуба в максимальном доступном качестве.
Для скачивания выберите вариант из формы ниже:
-
Информация по загрузке:
Cкачать музыку Dépistage de l'endométriose : un test salivaire sûr à 95% бесплатно в формате MP3:
Если иконки загрузки не отобразились, ПОЖАЛУЙСТА,
НАЖМИТЕ ЗДЕСЬ или обновите страницу
Если у вас возникли трудности с загрузкой, пожалуйста, свяжитесь с нами по контактам, указанным
в нижней части страницы.
Спасибо за использование сервиса video2dn.com

Информация по комментариям в разработке